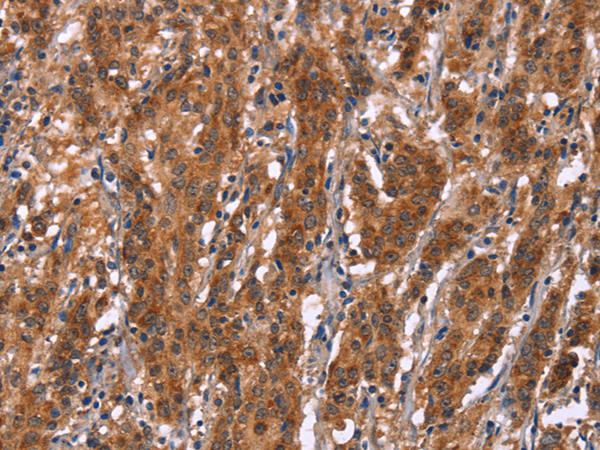

-
分类: 科研抗体货号: P04955别名: AF-1; IFGR2; IFNGT1应用: WB,IHC反应种属: Human, Mouse
-
分类: 科研抗体货号: P04902别名: GKRP; FGQTL5应用: WB,IHC反应种属: Human, Mouse, Rat
-
分类: 科研抗体货号: P04856别名: ERp28; ERp31; PDIA9; PDI-DB; C12orf8应用: WB,IHC反应种属: Human, Mouse, Rat
-
分类: 科研抗体货号: P04953别名: IDB4; bHLHb27应用: WB反应种属: Human, Mouse
-
分类: 科研抗体货号: P04852别名: CT71; CT72; WAP7; WFDC7; SPINLW1; dJ461P17.2应用: WB,IHC反应种属: Human, Mouse
-
分类: 科研抗体货号: P04900别名: BIR1; GIRK2; KATP2; KCNJ7; GIRK-2; KATP-2; KIR3.2; hiGIRK2应用: IHC反应种属: Human, Mouse, Rat
-
分类: 科研抗体货号: P04952别名: HEIR-1; bHLHb25应用: IHC反应种属: Human, Mouse, Rat
-
分类: 科研抗体货号: P04898别名: Geph应用: IHC反应种属: Human, Mouse, Rat
-
分类: 科研抗体货号: P04848别名: KS; KNO; KNO1应用: IHC反应种属: Human, Mouse
-
分类: 科研抗体货号: P04950别名: TLN; TLCN应用: WB,IHC反应种属: Human, Mouse

鄂公网安备42018502007531号
鄂公网安备42018502007531号

